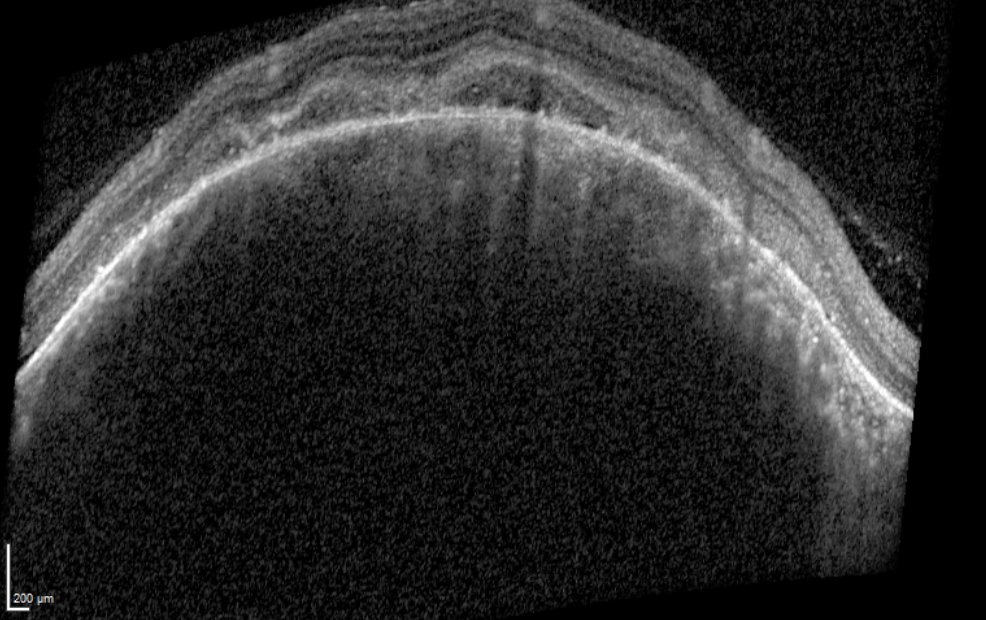

@65826o Antebe ilk taşındımızda Fluence baktık birtane arabanın arka taraf başka arabayanındı ön taraf baska arabanındı expre soktuk adam işciliği tebrik etti
Harbi uğraşılmıs dedi amk
430

DeepSeek R1 training cost on A100 via Fluence Cloud GPU: what a $30 fine-tune delivers, with real results, limits, and GPU cost insights.
From fluence.network
DeepSeek R1 training cost on A100 via Fluence Cloud GPU: what a $30 fine-tune delivers, with real results, limits, and GPU cost insights.
From fluence.network